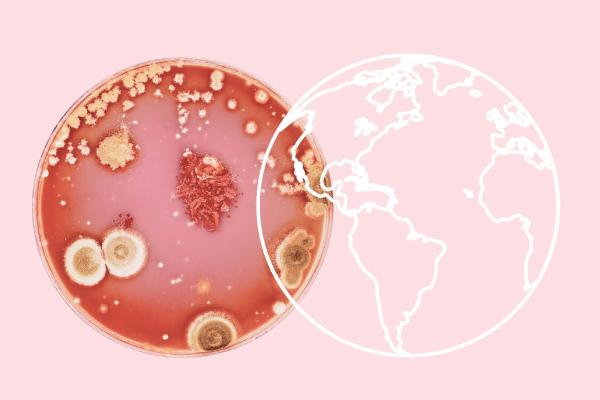

In this fascinating book, science author Toon Verlinden invites you to join him on a journey of discovery through the marvellous world of solar eruptions, volcanoes, viruses, and near-Earth asteroids.

Team members
Need resources for your own investigative story?
Journalismfund Europe's flexible grants programmes enable journalists to produce relevant public interest stories with a European mind-set from international, national, and regional perspectives.
Support independent cross-border investigative journalism
We rely on your support to continue the work that we do. Make a gift of any amount today.